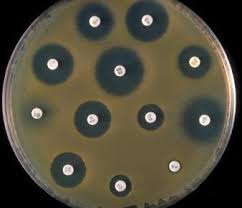
google imagens
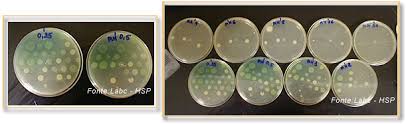
google imagens
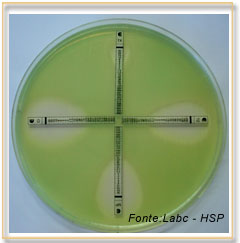
google imagens

Antibacterianos e Resistência
Antibacterianos
As drogas antimicrobianas podem ser classificadas como bactericidas ou bacteriostáticas. Enquanto os fármacos bactericidas atuam, eliminando o micro-organismo diretamente, os bacteriostáticos inibem o crescimento e a multiplicação bacteriana, possibilitando que as defesas imunológicas do hospedeiro eliminem os patógenos . Os agentes antimicrobianos, utilizados para o tratamento de infecções bacterianas, podem ser classificados, também, de acordo com o principal mecanismo de ação. Existem cinco principais modos de atuação:
1) inibição da síntese da parede celular.
2) inibição da síntese de proteínas.
3) desestabilização da membrana da célula bacteriana.
4) interferência na síntese de ácido nucleico.
5) inibição da síntese de folato.
Resistência
A resistência bacteriana aos antibióticos consiste em séries de mecanismos de adaptação que permitem ao micro-organismo resistir aos efeitos nocivos ou letais dos fármacos aos quais estão sendo expostos. A resistência pode ser intrínseca ao micro-organismo ou adquirida através do compartilhamento dos genes, que dão a bactéria receptora mecanismos que lhe confere resistência ao antimicrobiano . A emergência e disseminação de inúmeros micro-organismos resistentes resultam da combinação de múltiplos fatores, tais como: mutações dos genes de resistência, que aumentam o espectro de atividade, troca de informações genéticas nas quais os genes de resistência são transferidos para novos micro-organismos, pressão seletiva exercida pelas condições do meio, que favorece a emergência e disseminação de micro-organismos resistentes, proliferação e disseminação de clones multirresistentes, as quais podem ocorrer no nível global. Existem diversos mecanismos que conferem às bactérias resistência aos antimicrobianos, como:
1) enzimas que destroem ou modificam a estrutura química do agente antibacteriano, antes que possa ter efeito.
2) bombas de efluxo, levando a extrusão do agente antibacteriano.
3) alteração na estrutura das paredes ou membranas celulares bacterianas, modificando o local de ligação do agente antimicrobiano.
4) mutações que limitam o acesso
de agentes antimicrobianos ao local alvo.
Teste de Sensibilidade aos antimicrobianos
Técnica destinada à determinação da sensibilidade bacteriana in vitro frente a agentes antimicrobianos, também conhecido por antibiograma. Seve para : orientar a escolha da terapia antimicrobiana, monitorar a evolução da resistência bacteriana, garantir a eficácia antimicrobiana quando a sensibilidade não pode ser prevista, fornecer dados epidemiológicos, detectar e rastreia surtos e localizar cepas resistente.
-Método Qualitativo: Método de Disco-difusão.
Leitura por Zona de Inibição, que é o diâmetro do halo estéril em torno do disco, em placas semeadas com as mesmas cepas bacterianas.Utilizado na rotina Laboratorial, discos de papel-filtro impregnados com concentração padronizado, Meio: Mueller-Hinton, interpretação: halo de inibição do crescimento podendo ser:
• Sensível: Quando o isolado bacteriano é inibido in vitro por uma concentração de um antimicrobiano - alta probabilidade de éxito terapêutico.
• Intermediário: Quando o isolado bacteriano é inibido in vitro por uma concentração de um antimicrobiano - efeito terapêutico incerto.
• Resistente: Quando o isolado bacteriano é inibido in vitro por uma concentração de um antimicrobiano - alta probabilidade de fracasso terapêutico.
-Método Quantitativo : Macrodiluição em tubos, Microdiluição em caldo, Ágar diluição, Etest.
Leitura por Determinação da Concentração Inibitória Mínima(CIM),fornece a concentração mínima do agente antimicrobiano capaz de inibir 80-100% do crescimento do microrganismo em estudo. Se utiliza em infecções localizadas em sítios corpóreos: endocardite, osteomelite e meningite, infecções sistêmicas causadas por bactérias, multirresistentes, Infecções em pacientes imunocomprometidos.
1) Macrodiluição em tubos: método de referência, diluição seriada do antimicrobiano, quantitativo - CIM, leitura visual.
2) Microdiluição em caldo de cultura: CIM em menores volumes, placas de microdiluição, muito utilizado por pesquisadores.
3)Diluição em ágar: método de referência, CIM: placa com menor concentração capaz de inibir o crescimento.
4) Método do Etest: São fitas plásticas impregnadas com diferentes concentrações - escala de CIM (µg/ mL) impressa.
FONTES
- NOGUEIRA, Hadison Santos et al. Antibacterianos: principais classes, mecanismos de ação e resistência. Unimontes Científica, v. 18, n. 2, p. 96-108, 2017.
- ANVISA, Módulo 3: Resistência Microbiana - Mecanismos e Impacto Clínico, Disponível em : https://www.anvisa.gov.br/servicosaude/controle/rede_rm/cursos/rm_controle/opas_web/modulo3/mecanismos.htm , Acesso em : 26/05/2018.